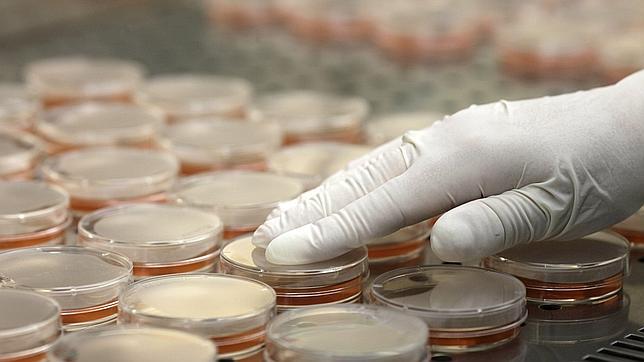
La UE aprueba los 210 millones de ayuda para los agricultores afectados por la «E. coli»

La UE aprueba los 210 millones de ayuda para los agricultores afectados por la «E. coli»
España, junto con otros tres países, vota en contra de la cantidad acordada por el comité de gestión de la Unión por considerarla «insuficiente»
MARIBEL NÚÑEZ
La mayoría de países de la Unión Europea ha votado esta tarde a favor de la propuesta de ayudas para el sector hortofrutícola realizada por la Comisión Europea la semana pasada y que asciende a 210 millones de euros , lo que supone la mitad ... del perjuicio causado al sector por la falsa acusación alemana de que estos productos eran transmisores de la variante mortal de la bacteria E. coli.
España, Francia, Polonia y Eslovaquia votaron en contra de la iniciativa, pero finalmente salió adelante porque no reunieron la mayoría necesaria para que Bruselas elevara la ayuda.
De este dinero, que estará disponible a finales de este mes, podrán beneficiarse los productores de pepinos, tomates, lechugas, calabacines y pimientos que vieron sus ventas reducirse a cero por la falsa alerta dada por Alemania. Para el resto del sector, como las frutas, no habrá ninguna ayuda.
Eduardo Tamarit, secretario general de Medio Rural, ha asegurado en Bruselas, al término de la reunión del Comité de Gestión de la UE, que la decisión no satisfacía a España «ya que las medidas no son suficientes y, además, no incluyen a todos el sector hortofrutícola sino sólo a cinco productos».
Pérdidas semanales de 200 millones
Los productores españoles de frutas y hortalizas habían cifrado en más de 200 millones de pérdidas a la semana por la situación creada en Alemania, que provocó la paralización de las exportaciones españolas no sólo al país germano sino a buena parte de los principales mercados europeos y a Rusia.
España, no obstante, podría optar por llevar este asunto de nuevo a la mesa del Consejo de Ministros de Agricultura de la Unión Europea, tal y como hizo la semana pasada en la reunión que hubo en Luxemburgo, aunque ya tendrá que hacer una reclamación individual o, como mucho, de la mano de Francia, para poder obtener un resultado mejor que el cosechado esta tarde en la capital comunitaria.
Noticias relacionadas
- La bacteria E. coli procede de brotes vegetales cultivados en Alemania
- Un niño de dos años, víctima mortal número 37 de la «E. coli» en Alemania
- La bacteria E. coli procede de brotes vegetales cultivados en Alemania
- Una empresa malagueña demanda a Hamburgo por la crisis de los pepinos
- Así mata la bacteria E.coli
Esta funcionalidad es sólo para suscriptores
Suscribete
Esta funcionalidad es sólo para registrados
Iniciar sesiónEsta funcionalidad es sólo para suscriptores
Suscribete